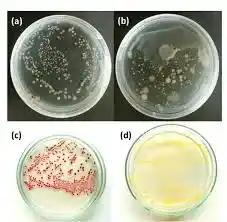

محیط کشت آکواپورین آگار (Aquaporin Agar) یکی از محیطهای کشت پیشرفته است که در سالهای اخیر به دلیل ویژگیهای منحصر به فرد خود در تشخیص و مطالعه میکروارگانیسمها و ترکیبات شیمیایی مرتبط، مورد توجه بسیاری از محققان و صنایع قرار گرفته است. این محیط کشت، که توسط شرکتهای برجستهای همچون مرک تولید میشود، به دلیل تواناییهای خاص در شناسایی فعالیتهای مرتبط با پروتئینهای آکواپورین و کاربردهای گسترده آن در آزمایشگاهها و صنایع شیمیایی، به یک ابزار اساسی تبدیل شده است.
وقتی صحبت از تحقیقات میکروبیولوژی و کشت میکروارگانیسمها به میان میآید، اولین چیزی که به ذهن پژوهشگران و دانشجویان میرسد کیفیت محیط کشت است. محیط کشتها نهتنها بستری برای رشد میکروبها فراهم میکنند، بلکه ترکیب دقیق و استاندارد آنها در نتیجه نهایی آزمایشها نقش تعیینکنندهای دارد. یکی از محیطهای پرکاربرد و استاندارد در این زمینه، محیط کشت آکواپورین آگار مرک است. این محیط کشت به دلیل فرمولاسیون دقیق، قابلیت رشد انتخابی میکروارگانیسمهای خاص و پایداری بالا، به یکی از گزینههای محبوب در دانشگاهها، صنایع دارویی و آزمایشگاههای تحقیقاتی تبدیل شده است.
اگر به دنبال خرید محیط کشت آکواپورین آگار مرک هستید، شیمی کهن با ارائه محصولی اورجینال از برند معتبر مرک و بستهبندی استاندارد، انتخابی مطمئن برای شماست.

ما اصالت کالا را تضمین میکنیم. محیط کشت آکواپورین آگار Merck/Sigma با برگه آنالیز (COA)، بستهبندی استاندارد و مشاوره تخصصی قابل ارائه است. هماکنون سفارش دهید.
برای خرید کاتالپول (Catalpol) کد: PHL89595 با شیمی کهن در ارتباط باشید.
021-66895887( تماس :8:30 الی 18)
واتساپ:09122885447 ( 24ساعت)
اگر شما یک دانشجو یا پژوهشگر دانشگاهی هستید، میتوانید کاتالپول (Catalpol) سیگما را با تضمین اصالت و بستهبندی استاندارد از فروشگاه ما تهیه کنید و پروژه تحقیقاتی خود را با اطمینان پیش ببرید.
تعریف آکواپورین آگار
محیط کشت آکواپورین آگار محیط کشتی است که برای مطالعه و تشخیص فعالیت آکواپورینها، پروتئینهایی که در جابجایی آب و مولکولهای کوچک در غشاهای سلولی نقش دارند، طراحی شده است. این محیط ترکیباتی خاص دارد که امکان شناسایی و مطالعه میکروارگانیسمها و فرایندهای وابسته به آکواپورین را فراهم میکند.
محیط کشت آکواپورین آگار مرک نوعی محیط کشت آماده است که بهطور اختصاصی برای بررسی رشد و شناسایی باکتریها و میکروارگانیسمهای وابسته به سیستمهای آبی و پروتئینهای غشایی مانند آکواپورینها طراحی شده است. این محیط ترکیبی از مواد غذایی، نمکها، منابع انرژی و آگار بهعنوان پایه ژلکننده است که امکان رشد بهینه میکروبها را فراهم میسازد.
شرکت شیمی کهن، نمایندگی محیط کشت در ایران می باشد. این مجموعه کلیه محصولات و مواد شیمیایی آزمایشگاهی را از جمله محصولات مرک merck ، و سیگماآلدریچ ، و محیط کشت و کلیه محصولات آزمایشگاهی و صنعتی را به مشتریان ارائه می دهد.
برندهای معتبر و فرم بستهبندی
-
برند اصلی: Merck (مرک آلمان)
-
بستهبندیها:
-
بطریهای ۵۰۰ گرمی برای استفاده آزمایشگاهی
-
بستههای ۱ کیلویی برای مصارف گستردهتر
-
امکان تأمین در مقیاس عمده برای صنایع دارویی
-
مشخصات شیمیایی و فیزیکی
مشخصات شیمیایی
- مواد پایه:
- آگار: به عنوان پایه ژلاتینی.
- پپتون: به عنوان منبع نیتروژن و مواد مغذی.
- ترکیبات شیمیایی خاص برای فعالسازی آکواپورینها.
- نشانگرهای زیستی برای شناسایی فعالیتهای مرتبط.
- pH: معمولاً در محدوده 7.0 تا 7.5 تنظیم میشود تا شرایط ایدهآل برای فعالیت میکروارگانیسمها و آنزیمها فراهم شود.
مشخصات فیزیکی
- رنگ: معمولاً شفاف یا کمی مات.
- حالت: جامد (ژلمانند).
- حلالیت: به راحتی در آب حل میشود و پس از گرم شدن به صورت ژل درمیآید.
ویژگیها محیط کشت آکواپورین آگار مرک
- تخصصی بودن: طراحی شده برای مطالعه فعالیتهای مرتبط با آکواپورینها.
- دقت بالا: امکان شناسایی دقیق عملکرد پروتئینهای غشایی.
- پایداری: مقاوم در برابر تغییرات دما و pH در شرایط آزمایشگاهی.
- سازگاری بالا: قابل استفاده برای انواع مختلفی از میکروارگانیسمها.
کاربردها محیط کشت آکواپورین آگار مرک در صنعت شیمیایی
- مطالعه عملکرد غشاهای زیستی: بررسی نقش آکواپورینها در فرآیندهای جابجایی آب و مواد محلول.
- تصفیه آب: مطالعه کارایی آکواپورینها در غشاهای صنعتی تصفیه آب.
- صنایع دارویی: شناسایی نقش آکواپورینها در انتقال داروها و مواد فعال زیستی.
- بیوتکنولوژی: تولید غشاهای مصنوعی با الهام از عملکرد آکواپورینها.
کاربردها در آزمایشگاه
- آزمایشگاههای زیستشناسی مولکولی: بررسی عملکرد آکواپورینها در غشاهای سلولی.
- آزمایشگاههای میکروبیولوژی: شناسایی میکروارگانیسمهای مرتبط با فرآیندهای وابسته به آب.
- کنترل کیفیت: بررسی کیفیت محصولات مرتبط با آکواپورینها در صنایع مختلف.
نحوه آزمایش محیط کشت آکواپورین آگار مرک
- آمادهسازی محیط کشت:
- مقدار مشخصی از پودر آکواپورین آگار را با آب مقطر مخلوط کرده و حرارت دهید تا محلول یکنواختی به دست آید.
- محلول را استریل کنید و به پتری دیش انتقال دهید.
- کشت نمونه:
- نمونه مورد نظر (مانند سلولها یا میکروارگانیسمها) را روی محیط کشت قرار دهید.
- پتری دیش را در انکوباتور با دمای مناسب (معمولاً 37 درجه سانتیگراد) قرار دهید.
- بررسی نتایج:
- تغییرات رنگ یا رشد کلنیها را بررسی کنید که نشاندهنده فعالیت آکواپورینها است.
محیط کشت چیست ؟
محیط کشت به محیط هایی گفته می شود که بصورت تخصصی برای رشد و تکثیر باکتریها یا سلولها تهیه شده اند و برای این منظور مورد استفاده قرار می گیرند. این محیط ها حاوی مواد خاصی هستند که محیط را برای رشد و تکثیر سلول ها مهیا می کنند.از این مواد می توان به قندها، نمکها، آب و غیره اشاره نمود. جهت خرید محیط کشت می توانید با بخش فروش شرکت شیمی کهن تماس حاصل بفرمایید.
ساختار و فرآیند تولید محیط کشت آکواپورین آگار مرک
مواد اولیه
- پپتون و آگار: برای تغذیه و ساختاردهی.
- ترکیبات آکواپورین فعال: برای شناسایی فعالیتها.
- بافرها: حفظ pH ثابت.
فرآیند تولید
- ترکیب مواد اولیه: در شرایط کنترلشده.
- استریلیزاسیون: حذف آلودگیهای میکروبی.
- بستهبندی: در شرایط استریل برای حفظ کیفیت.
مزایا
- افزایش دقت: شناسایی سریع و دقیق فعالیت آکواپورینها.
- قابلیت تنظیم: امکان تغییر ترکیبات برای کاربردهای خاص.
- کاهش زمان و هزینه: در مقایسه با روشهای پیچیدهتر.
معایب
- هزینه بالا: به دلیل ترکیبات خاص.
- نیاز به تجهیزات پیشرفته: برای تحلیل دقیق نتایج.
- محدودیت در کاربرد: بیشتر مناسب برای موارد تحقیقاتی خاص.
خواص محیط کشت آکواپورین آگار مرک
- پایداری بالا: مقاومت در برابر شرایط محیطی مختلف.
- سهولت استفاده: آمادهسازی و کاربرد آسان.
- تخصصی بودن: مناسب برای تحقیقات پیشرفته زیستشناسی و شیمیایی.
خواص شیمیایی و ایمنی
-
خواص شیمیایی:
-
دارای ترکیبات غذایی مناسب برای رشد باکتریهای مرتبط با آکواپورین
-
قابلیت تنظیم غلظت برای اهداف مختلف آزمایشگاهی
-
پایداری در شرایط اتوکلاو برای استریلسازی
-
-
ایمنی:
-
در دسته مواد کمخطر آزمایشگاهی قرار دارد
-
باید در محیط خشک و دور از رطوبت نگهداری شود
-
هنگام تهیه محلول، استفاده از ماسک و دستکش توصیه میشود.
-
کاربردها در صنعت و تحقیقات آزمایشگاهی
-
میکروبیولوژی پزشکی: برای شناسایی باکتریهای مرتبط با مسیرهای آبی در بدن
-
بیوتکنولوژی: در مطالعات پروتئینهای غشایی مانند آکواپورین
-
صنایع دارویی: جهت بررسی تأثیر داروها بر میکروارگانیسمهای آبی
-
دانشگاهی: در آزمایشگاههای میکروبشناسی برای آموزش و پژوهش دانشجویان
-
کیفیت آب: بررسی سلامت آب آشامیدنی و منابع آبی
نتیجهگیری
محیط کشت آکواپورین آگار یکی از ابزارهای نوین و تخصصی در تحقیقات زیستشناسی و شیمیایی است. این محیط با ویژگیهای منحصر به فرد خود، به محققان امکان میدهد تا فرآیندهای وابسته به آکواپورینها را با دقت بالا مطالعه کنند. با وجود هزینههای نسبی بالا، مزایای بیشمار آن در بهبود کیفیت تحقیقات و محصولات صنعتی، این محیط کشت را به یک انتخاب ارزشمند تبدیل کرده است.
راهنمای خرید و شرایط
برای خرید محیط کشت آکواپورین آگار مرک از شیمی کهن کافیست:
-
نوع بستهبندی مورد نظر (۵۰۰ گرمی یا ۱ کیلویی) را انتخاب کنید
-
سفارش خود را بهصورت آنلاین ثبت کنید
-
از مشاوره رایگان کارشناسان ما بهرهمند شوید
-
محصول در کوتاهترین زمان و بستهبندی ایمن به دست شما خواهد رسید.
سؤالات متداول
۱. آیا این محیط برای تمام میکروارگانیسمها مناسب است؟
خیر، بیشتر برای باکتریها و میکروبهای مرتبط با سیستمهای آبی طراحی شده است.
۲. آیا میتوان محیط آماده را فریز کرد؟
خیر، بهترین شرایط نگهداری در دمای اتاق و محیط خشک است.
۳. آیا خرید بهصورت عمده امکانپذیر است؟
بله، شیمی کهن تأمینکننده عمده محصولات مرک برای دانشگاهها و صنایع است.
۴. آیا محصول دارای ضمانت اصالت است؟
بله، تمامی محصولات با گارانتی اصالت و تاریخ انقضا عرضه میشوند.
خرید محیط کشت آکواپورین آگار مرک
شرکت شیمی که نمایندگی سیگماآلدریچ در ایران با همکاری کارشناسان مجرب خود در بخش فنی و فروش جهت تامین مواد اولیه پژوهش های تحقیقاتی ماده با کیفیت بالا و قیمت مناسب را فراهم نموده است. شما می توانید جهت خرید محیط کشت آکواپورین آگار مرک با بخش فروش شرکت شیمی کهن تماس حاصل بفرمایید و پس از دریافت پیش فاکتور و اطمینان حاصل کردن از صحیح بودن شماره CAS نامبر مواد شیمیایی درخواستی اقدام به ثبت سفارش نمایید تحویل کالاهای خریداری شده و زمان تحویل آنها به صورت زیر می باشد.
ارسال کالاهای موجود در انبار: ۲۴ تا ۴۸ ساعت کاری می باشد.
روش ارسال کالا مشتریان تهران: ارسال توسط پیک
ارسال مشتریان سایر شهرها
توسط شرکت های حمل و نقل ( تیپاکس– پست– ترمینال )

قیمت فروش محیط کشت آکواپورین آگار مرک
شرکت شیمی کهن یکی از بزرگترین وارد کنندگان و فروشندگان مواد شیمیایی آزمایشگاهی بخصوص فروش محیط کشت آکواپورین آگار مرک می باشد. این شرکت در زمینه واردات محصولات سیگما از تجربه بسیار بالایی برخوردار است. شما می توانید جهت خرید محصولات نمایندگی مرک آلمان و تهیه این محصول (اصلی) با بخش فروش شرکت تماس گرفته و با کارشناسان این شرکت در ارتباط باشید.
همچنین از طریق کانال واتساپ شرکت نام محصول را به همراه میزان نیاز خود ارسال کنید. در کمترین زمان ممکن پاسخ استعلام خود را دریافت نمائید. امیدواریم بتوانیم با ارائه محصولات اصلی و با بهترین کیفیت شما را برای رسیدن به اهدافتان یاری نمائیم.
جهت محصولات بیشتر در نمایندگی مرک و استعلام سریع قیمت محیط کشت آکواپورین آگار مرک میتوانید ازطریق کانال واتساپ شرکت با ارسال نام ماده و مقدار نیاز درکمترین زمان پاسخ استعلام خود رادریافت نمائید.
راههای ارتباطی :
021-66895887 (ساعات تماس:8:30 الی 19)
واتساپ:09122885447 (ساعات تماس 24ساعت)